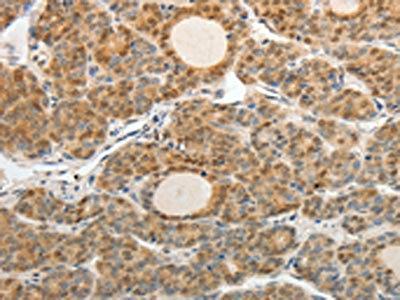

ASCL1 Antibody
-
中文名稱:ASCL1兔多克隆抗體
-
貨號(hào):CSB-PA298683
-
規(guī)格:¥1100
-
圖片:
-
The image on the left is immunohistochemistry of paraffin-embedded Human ovarian cancer tissue using CSB-PA298683(ASCL1 Antibody) at dilution 1/30, on the right is treated with synthetic peptide. (Original magnification: ×200)
-
The image on the left is immunohistochemistry of paraffin-embedded Human thyroid cancer tissue using CSB-PA298683(ASCL1 Antibody) at dilution 1/30, on the right is treated with synthetic peptide. (Original magnification: ×200)
-
-
其他:
產(chǎn)品詳情
-
Uniprot No.:
-
基因名:
-
別名:Achaete scute complex homolog 1 antibody; Achaete scute complex homolog like 1 antibody; Achaete scute complex homologue 1 antibody; Achaete scute complex homologue like 1 antibody; Achaete scute complex like 1 antibody; Achaete scute family bHLH transcription factor 1 antibody; Achaete scute protein antibody; Achaete-scute homolog 1 antibody; Ascl 1 antibody; ascl1 antibody; ASCL1_HUMAN antibody; Ash 1 antibody; ASH-1 antibody; Ash1 antibody; bHLHa46 antibody; Class A basic helix-loop-helix protein 46 antibody; Hash 1 antibody; HASH1 antibody; Mammalian achaete scute homolog 1 antibody; Mammalian achaete scute homologue 1 antibody; Mash 1 antibody; Mash1 antibody
-
宿主:Rabbit
-
反應(yīng)種屬:Human,Mouse,Rat
-
免疫原:Synthetic peptide of Human ASCL1
-
免疫原種屬:Homo sapiens (Human)
-
標(biāo)記方式:Non-conjugated
-
抗體亞型:IgG
-
純化方式:Antigen affinity purification
-
濃度:It differs from different batches. Please contact us to confirm it.
-
保存緩沖液:-20°C, pH7.4 PBS, 0.05% NaN3, 40% Glycerol
-
產(chǎn)品提供形式:Liquid
-
應(yīng)用范圍:ELISA,IHC
-
推薦稀釋比:
Application Recommended Dilution ELISA 1:3000-1:10000 IHC 1:50-1:200 -
Protocols:
-
儲(chǔ)存條件:Upon receipt, store at -20°C or -80°C. Avoid repeated freeze.
-
貨期:Basically, we can dispatch the products out in 1-3 working days after receiving your orders. Delivery time maybe differs from different purchasing way or location, please kindly consult your local distributors for specific delivery time.
-
用途:For Research Use Only. Not for use in diagnostic or therapeutic procedures.
相關(guān)產(chǎn)品
靶點(diǎn)詳情
-
功能:Transcription factor that plays a key role in neuronal differentiation: acts as a pioneer transcription factor, accessing closed chromatin to allow other factors to bind and activate neural pathways. Directly binds the E box motif (5'-CANNTG-3') on promoters and promotes transcription of neuronal genes. The combination of three transcription factors, ASCL1, POU3F2/BRN2 and MYT1L, is sufficient to reprogram fibroblasts and other somatic cells into induced neuronal (iN) cells in vitro. Plays a role at early stages of development of specific neural lineages in most regions of the CNS, and of several lineages in the PNS. Essential for the generation of olfactory and autonomic neurons. Acts synergistically with FOXN4 to specify the identity of V2b neurons rather than V2a from bipotential p2 progenitors during spinal cord neurogenesis, probably through DLL4-NOTCH signaling activation. Involved in the regulation of neuroendocrine cell development in the glandular stomach.
-
基因功能參考文獻(xiàn):
- We address this paradox using basic helix-loop-helix (bHLH) transcription factors ASCL1, ASCL2, and MYOD1, crucial mediators of lineage specification..Although the ASCL factors and MYOD1 have some distinct DNA motif preference, it is not sufficient to explain the extent of the differential binding. All three factors can bind inaccessible chromatin and induce changes in chromatin accessibility and H3K27ac PMID: 29500235
- a large subset of patient-derived glioblastoma stem cells (GSCs) express high levels of Achaete-scute homolog 1 (ASCL1), a proneural transcription factor involved in normal neurogenesis. PMID: 28712938
- System analysis identified distinct and common functional networks governed by transcription factor ASCL1, in glioma and small cell lung cancer. PMID: 28742165
- Results indicate transcription factor Ascl1 protein functionalized with intracellular protein delivery technology (Ascl1-IPTD) as a powerful tool for engineering neural tissue from pluripotent stem cells. PMID: 27138845
- knocking down achaete-scute complex homologue-1 expression could significantly suppress the proliferation, migration, and invasion of laryngeal carcinoma cell in vitro and disorder epithelial-mesenchymal transformation-associated protein expression. PMID: 28618959
- we found that CpG_6.7.8 of the achaete-scute homolog 1 CpG island is frequently hypermethylated in early-stage pulmonary neuroendocrine tumors, and this aberrant hypermethylation is negatively correlated with achaete-scute homolog 1 expression in this tumor spectrum PMID: 28621224
- the first comprehensive high-resolution information on the structural propensities and conformational dynamics of Ascl1, is reported. PMID: 28402879
- ASCL1 expression may determine the cell behaviors of SCLC partly through modifying EMT phenotypes. PMID: 27785690
- This report identifies novel roles for the transcription factor Ascl1 in enteric gliogenesis and neurogenesis PMID: 27076429
- ASCL1 expression is regulated by BRD4 is frequently overexpressed in small cell lung cancer. PMID: 26253517
- Data show that chrysin suppressed cell proliferation and reducing expression of achaete-scute complex-like 1 (ASCL1) and the neuroendocrine biomarker chromogranin A (CgA). PMID: 26403073
- hASH1 is a specific marker to distinguish neuroendocrine tumors from squamous cell carcinomas and adenocarcinomas PMID: 26596584
- marker for neurogenic potential in cultured retinal progenitor cells PMID: 26292211
- Achaete-scute homolog 1 (ASCL1), a transcription factor required for proper development of pulmonary neuroendocrine cells, is essential for the survival of a majority of lung cancers with neuroendocrine features. PMID: 25267614
- data suggest that a prominent down-regulation of hnRNP-A2/B1 during hypoxia is associated with the post-transcriptional suppression of hASH1 synthesis. PMID: 25124043
- ASCL1 and RET expression defines a clinically relevant subgroup of lung adenocarcinoma characterized by neuroendocrine differentiation. PMID: 24037524
- lentiviral overexpression of transcription factors ASCL1, SOX10, and NKX2.2 in NPCs was sufficient to induce Sox10 enhancer activity, OPC mRNA, and protein expression consistent with OPC fate PMID: 24982138
- ASCL1 Promotes Wnt Signaling Directly by Repressing DKK1. PMID: 23707066
- BRN2 is a higher level regulator than ASCL1 and ND1 and BRN2 might be involved in aggressiveness of small cell lung cancer. PMID: 23530560
- Gene expression profiling revealed that permissive lines are typified by lower expression of the early neurogenic transcription factor ASCL1 and, conversely, by higher expression of the late neurogenic transcription factor NEUROD1. PMID: 23739064
- ASH1 overexpression in prostate cancer cells promotes neuroendocrine differentiation and increased cell viability. PMID: 23657976
- Achaete-scute homolog 1 may be proposed as a diagnostic marker of poor differentiation and may help to differentiate neuroendocrine carcinomas from neuroendocrine tumors in difficult cases. PMID: 23375646
- Ascl1 modulates multiple steps of oligodendrocyte precursor cell development in the postnatal brain and in response to demyelinating insults. PMID: 23739972
- Ascl1 directly regulates expression of matrix metalloproteinase-7 and O(6)-methylguanine-DNA methyltransferase. PMID: 23300791
- The ASCL1 knock-down gene set also classified the 171 adenocarcinomas into three subtypes and this NE subtype also had the poorest prognosis. PMID: 21737174
- Among human primary tumors, 2/2 SCLC, 5/5 pulmonary carcinoids, and 10/41 non-SCLC (only 4 of which had NE features) were positive for hASH1 by immunohistochemistry and RNA-RNA in situ hybridization. PMID: 21684625
- hASH-1 expression occurs in breast cancers with neuroendocrine differentiation regardless of the extent of the NE cell population, and it is restricted to a subset of tumor cells having a low proliferative potential. PMID: 22422124
- Dual-luciferase assays showed that ASCL1 activated the expression of miR-375 by binding to the three E-box elements in the miR-375 promoter. These results imply a role of ASCL1 in SCLC via the upregulation of miR-375. PMID: 22172490
- miR-375 is a key downstream effector of ASH1 function in lung cancer cells PMID: 21856745
- The present results suggest that a transcriptional complex of LMO3 and HEN2 may contribute to the genesis and malignant phenotype of neuroblastoma by inhibiting HES1 which suppresses the transactivation of Mash1. PMID: 21573214
- HASH1 down-regulation is associated with cell proliferation, thereby resulting in uterine carcinogenesis. PMID: 21495212
- ASCL1-pathway is responsible for the up-regulation of IGF2 during neuroblastoma differentiation. PMID: 20842449
- deletional rearrangement of the TCR delta gene disrupted the hypothetical gene C12orf42 and brought the Achaete-scute complex homolog 1 gene into proximity of the TRA enhancer, which is overexpressed in thyroid and lung cancers PMID: 20659153
- hASH1 is a new kind of highly specific markers of pulmonary neuroendocrine tumours, and may be applied to clinical pathology diagnosis of the pulmonary neuroendocrine tumors. PMID: 20677557
- report the analysis of 9 highly conserved putative enhancers in a 64kb interval encompassing the human ASCL1 locus PMID: 20206680
- Supratentorial PNETs expressed significantly higher levels of SOX2, NOTCH1, ID1, and ASCL-1 transcripts. PMID: 20515335
- Our data indicate a specific role for ASCL1 in regulating the expression of the CHRNA5/A3/B4 lung cancer susceptibility locus. This regulation may contribute to the predicted role that ASCL1 plays in SCLC tumorigenesis. PMID: 20124469
- these support the role of the polyglutamine length variants in the MASH1 gene in Parkinson's disease susceptibility. PMID: 20097173
- HASH1 mRNA expression levels in SCLC clinical samples were 1,000-fold higher than in the NSCLC samples, and this method could contribute to diagnosis based on molecular profiling of tumors. PMID: 11948117
- We also studied the proneural HASH-1 gene and identified a heterozygous nucleotide substitution in three CCHS patients PMID: 14532329
- HASH1 appears to be important in the endocrine phenotype of medullary thyroid carcinoma (MTC) tumors and may serve as a molecular target for the treatment of patients with MTC. PMID: 14668716
- ASH1 is a neuroendocrine marker whose expression is largely conserved in normal and neoplastic pituitary cells. PMID: 14759067
- the hASH1 mRNA level might represent a useful tool for distinguishing esthesioneuroblastoma from poorly differentiated tumors of the sinonasal region PMID: 15272537
- Up-Regulation of ASCL1 is associated with gastrointestinal neuroendocrine carcinomas PMID: 15701827
- The present genetic data may thus suggest that polyglutamine length polymorphisms in ASCL1 could influence predispositions to PD through the fine-tuning of LC integrity. PMID: 16021468
- RaF-1 activation causes cessation of hASH-1 expression PMID: 16029117
- Upregulation of ASCL1 and inhibition of Notch signaling pathway characterize progressive astrocytoma PMID: 16103883
- Knockdown of ASH1 gene in lung neoplasm cells in vitro suppressed growth by increasing apoptosis. PMID: 17507989
- In prostate cancers with neuroendocrine differentiation...hASH1 transcript levels in androgen deprivation-treated compared with untreated patients PMID: 18311112
- ASH1 functions as a dual transcription factor by activating neuroendocrine differentiation markers and also repressing putative tumor suppressors. PMID: 18339843
顯示更多
收起更多
-
亞細(xì)胞定位:Nucleus.
-
數(shù)據(jù)庫(kù)鏈接:
Most popular with customers
-
-
YWHAB Recombinant Monoclonal Antibody
Applications: ELISA, WB, IHC, IF, FC
Species Reactivity: Human, Mouse, Rat
-
Phospho-YAP1 (S127) Recombinant Monoclonal Antibody
Applications: ELISA, WB, IHC
Species Reactivity: Human
-
-
-
-
-